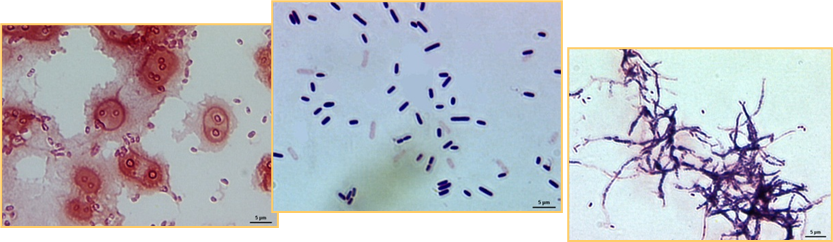
image

Jak překlopit prezentace z Powerpointu do OrgPadu?
Created by Nikol Vypior (osobní/personal)

Interaktivní schéma ČOV
Mechanický stupeň ČOV
- česle, síta, mikrosíta, mikrofiltry
- lapák písku, lapák tuků a plovoucích nečistot
- usazovací nádrže
Biologický stupeň ČOV

Substrát
organická hmota nebo živiny likvidována během biologického čištění
Cíl biologického čištění
- koagulovat a odbourat neusaditelné koloidní látky
- stabilizovat organické látky
U komunálních odpadních vod:
- redukce organických látek
- redukce nutrientů (N a P)
Téměř všechny odpadní vody mohou být bilogicky čištěny.
Enzymy
- sehrávají mimořádnou roli v růstu a příjmu energie.
- organické katalyzátory produkovanéživými buňkami
- jsou to proteiny nebo proteiny kombinované s anorganickými molekulami nebo s organickými molekulami s malou molekulárníhmotou.
- urychlují chemické reakce

Růst a rozmnožování mikroorganismů
Dělení fází růstu:
1.Fáze růstu - nadbytek substrátu, rychlost metabolismu a růstu je pouze závislá na schopnosti mikroorganismu zpracovávat substrát
2.Fáze omezeného růstu - rychlost růstu se snižuje v důsledku omezení substrátu
3.Endogenní fáze - mikroorganismy jsou nuceny využívat svou vlastní protoplasmu neboť koncentrace substrátu je minimální. Živiny z mrtvých buněk jsou uvolňovány a využity zbývajícími buňkami.
Růstová křivka:

Procesy s biologickou kulturou ve vznosu:
1)aktivační proces
2)nitrifikační proces
3)provzdušňované laguny
4)aerobní stabilizace
5)vysoko zatížené biologické rybníky
(stabilizační nádrže)
Mikroorganismy
Role:
biologické odbourávání znečištění za vzniku:
- různých plynů
- vody
- buněčné hmoty se specifickou hmotností o něco vyšší nežli voda → oddělena gravitačně sedimentací.

Historie AP
1914 Ardern a Lockett (Anglie)
- Jako první začali využívat vločkovité suspenze, vzniklé v dlouhodobě provzdušňované odpadní vodě.
- Pozorovali, že se stoupající koncentrací suspenze se zkracoval proces čištění (ze dnů až na hodiny).
- Kal se choval aktivně ve smyslu odstraňování organického znečištění z odpadních vod Þ byl nazván aktivovaným kalem (activated sludge).
Aktivační proces
- provzdušňovaná AN → čistící proces → tvorba aktivovaného kalu
- surová / odsazená odpadní voda + VK = nátok do AN
- aerobní bakterie → potřeba kyslíku (v anoxických podmínkách pak dusitany a dusičnany)
- aerace - mechanická (zastaralé) nebo tlakový vzduch
- separace aktivovaného kalu od vyčištěné odpadní vody → DN
- VK → vyšší koncentrace biomasy v biologickém reaktoru
- PK → zpracován v kalovém hospodářství


Základní typy AP
Rozdělení aktivačních systémů podle zatížení
- aktivační systémy dělíme na nízko, středně a vysoko zatížené
- typické hodnoty zatížení kalu pro aktivační proces jsou v rozmezí 0,05 až 1,0 kg/kg/d
- pro dosažení kvalitního odtoku z hlediska odstranění organických látek dostačující stáří kalu od 3 do 15 dnů

Složení aktivovaného kalu
závisí hlavně na:
- složení substrátu, na němž byl kal vypěstován
- hodnotách technologických parametrů během kultivace (doba zdržení, zatížení, stáří kalu).
Vláknité mikroorganismy
Sphaerotilus, Nocardia, pirulina albida
Aktivovaný kal
Baktérie - Pseudomonas, Flavobacterium, Achrommobacter, Chromobacterium, Acinetobacter, Nocardia
Houby, plísně a kvasinky - přítomny v menším množství
Aktivovaný kal
- je schopen rušené sedimentace
- dobrá flokulace a sedimentace vloček je jednou z nejcennějších vlastností směsné kultury


Směsná kultura
- Směsná bakteriální kultura obsahující i jiné organizmy (houby, plísně, kvasinky, prvoky a některé vyšší mikroorganismy),
- Bakterie se v aktivovaném kalu vyskytují převážně ve formě zoogleí
- Z bakterií se nejčastěji vyskytují následující rody :
Pseudomonas, Flavobacterium, Achromobacter, Chromobacterium, Azotobacter, Micrococcus, Bacillus, Alcaligenes, Arthrobacter, Acinetobacter, Mycobacterium, Nocardia, Lophomonas aj.
- Nitrifikační bakterie Nitrosomonas a Nitrobacter.
- Vláknité mikroorganismy (pokud převládnou pak způsobují značné technologické potíže).
- Z vyšších organismů jsou přítomny prvoci, vířníci, hlístnice, protozoa aj. Prvoci snižují obsah volně pohyblivých bakterií Þ vyčiření vyčištěné odpadní vody.
Prvoci
Vorticella, Epistylis
Vyšší organismy
Protozoa, Vířníci, Hlístice
Flokující aktivovaný kal
- Optimální podmínky kultivace → aktivovaný kal ve formě dobře flokulujících a sedimentujících vloček.
- Tvorba vloček:
- není bezpodmínečně nutná pro účinné odstranění rozpuštěných organických látek z čištěné odpadní vody,
- je nutná pro získání čirého odtoku vyčištěné odpadní vody a dostatečně zahuštěného recirkulovaného aktivovaného kalu.
Bioflokulace
- zajišťuje agregaci (shlukování) mikroorg. do vloček
- následek interakce mezi přirozeně produkovanými vysokomolekulární polyelektrolyty a bakteriálními buňkami
- určitý podíl se připisuje rovněž snížení elektrického náboje na povrchu mikroorganismů pod kritickou hladinu
Neflokující aktivovaný kal (Disperzní růst)
Určité podmínky způsobí :
- ukončení procesu aglomerace mikroorganismů aktivovaného kalu a tvorby usaditelných vloček,
- mikroorganismy se vyskytují ve formě jednotlivě dispergovaných buněk,
- silně zakalený odtok vykazující vysoké hodnoty BSK5 a CHSK (obsah organických látek může být velmi malý).
Příčiny disperzního růstu :
- nevhodné technologické parametry procesu (vysoké zatížení kalu a nízké stáří kalu),
- složení a vlastnosti čištěné odpadní vody (nárazové změny teploty, pH, nedostatek makro a mikronutientů, přítomnost různých toxických látek organických i anorganických)
Zbytnělý aktivovaný kal
- nízké usazovací rychlosti Þ špatné sedimentační vlastnosti
- posouzení sedimentačních a zahušťovacích vlastností podle kalového indexu (definice níže)
- Podle velikosti KI rozdělujeme aktivované kaly do tří kategorií :
- normální KI < 100 ml.g-1,
- lehký KI = 100 – 200 ml.g-1,
- zbytnělý KI > 200 ml.g-1.
Nevláknité bytnění
- příčiny nejsou dosud jednoznačně objasněny (předpoklad = silná hydratace syntetizovaných extracelulárních polymerů)
- není v praxi častý a nezpůsobuje výrazné provozní potíže
Vláknité bytnění
- vyvolané nadměrným růstem vláknitých mikroorganismů
- různé příčiny jejich masového rozvoje ve směsné kultuře (v závislosti na růstových podmínkách a růstových rychlostech)
- v praxi způsobuje výrazné provozní potíže
Faktory podporující růst vláknitých organismů :
- složení čištěné odpadní vody (vyšší obsah sacharidů, sulfidů, nedostatek nutrientů, nízké pH),
- aktuální koncentrace rozpuštěného kyslíku v aktivační nádrži,
- aktuální koncentrace rozpuštěného substrátu (podporující růst mikroorganismů),
- technologické parametry procesu (zatížení, stáří kalu).
Opatření proti bytnění
Kinetická selekce organismů
- Vychází z rozdílné závislosti rychlosti růstu organizmů (m -specifická růstová rychlost) na koncentraci substrátu (S)
Princip selekce mikroorganismů ve směsné kultuře:
- Křivka A : KS = 20 g.m-3, mmax =1,0 h-1, Vláknité mikroorganismy
- Křivka B : KS = 1 g.m-3, mmax =0,5 h-1, Nevláknité mikroorganismy

Aktivace s postupným krokem (klasická aktivace)
- dlouhé koryto a relativně malým průtočným profilem
- odpadní voda se mísí s vratným aktivovaným kalem na začátku aktivační nádrže
- koncentrace aktivovaného kalu v nádrži se podstatně neliší
- koncentrace rozpuštěných organických látek po délce nádrže směrem k odtoku klesá
- rychlost spotřeby kyslíku látek po délce nádrže směrem k odtoku klesá

Odstupňovaná aktivace (Tapered Aeration)
- modifikace kl. aktivace (aktivace s postupným tokem)
- rychlost spotřeby a koncentrace kyslíku klesá postupně podél nádrže ve směru průtoku současně s poklesem koncentrace organického znečištění
- začátek nádrže Þ více provzdušňovacích elementů
- systém je provozován při stejných parametrech jako klasická aktivace

Směšovací kativace
- zpravidla nádrže čtvercového tvaru
- provzdušňované a míchané
- konstantní rozložení koncentrace aktivovaného kalu i rozpuštěného kyslíku v celé nádrži
- odolnost proti toxickým látkám díky okamžitému zředění koncentrace na přítoku
- podporuje růst vláknitých mikroorganismů (nevýhoda)

Postupně zatěžovaná aktivace (Step aeration)
- odpadní vody se přivádí v několika místech podél nádrže → vyrovná zatížení nádrže, a tím i rychlost, spotřeby kyslíku v nádrži,
- koncentrace aktivovaného kalu je v různých místech nádrže různá, z hydraulického hlediska se jedná o přechod mezi aktivací směšovací a aktivací s postupným tokem.

Aktivace s oddělenou regenerací kalu (Contact Stabilization)
- organické látky, zvláště koloidní se odstraňují především adsorpcí,
- relativně krátká doba provzdušnění v aerační (0,5 až 1 h),
- z dosazovací nádrže se vede vratný kal do regenerační nádrže (zde se provzdušňuje 2 až 4 hodiny),
- látky zachycené v kalu jsou oxidovány, přičemž dochází k vyčerpání zásobních látek, a tím se obnovuje adsorpční schopnost kalu a jeho akumulační kapacita,
- regenerovaný aktivovaný kal se přivádí do aktivační nádrže

Oxidační příkop s povrchovými aerátory
- tvořen uzavřeným žlabem, hloubky cca 1m
- provzdušňovaný mechanickým aeračním válcem (při větší délce žlabu bývá těchto aerátorů několik)






Attached-growth
= biofilmový systém
mikroorganismy jsou tzb. mobilizované - připojené, přisedlé apod. k nějakému nosiči

Disimilační a asimilační proces
Disimilace - příjem a akumulace energie Asimilace - produkce buněčné hmoty

Suspended-growth
= směsná kultura ve vznosu
mikroorganismy jsou v suspenzi ve vodě






































































Sdílení s ostatními - jednotlivci i týmy
Každá OrgStránka, kterou vytvoříte je primárně soukromá, dokud ji nezveřejníte nebo nenasdílíte.
Sdílet lze uživatelům v OrgPadu nebo pomocí odkazu či QR kódu ve sdílecím dialogu.
Uživatelům můžete nastavit práva - pro čtení, komentování nebo editaci či dokonce správu OrgStránky.
Zároveň si můžete vytvořit tým s Vašimi kolegy, kamarády nebo studenty či vyučujícími.
Lehce jde doplnit o další online prvky
Jako např. video na YT, animace z webu nebo rovnou samotné webové stránky. Této možnosti se říká embedování, které lze aplikovat kdekoli na webu.
V této OrgStránce se můžete podívat na příklady toho, co vše lze embedovat do OrgPadu. Mimochodem lze embedovat i samotné OrgStránky. Koukněte na další stránku teté buňky, aby jste navštívili výše nalinkovanou OrgStránku. →
v Powerpointu: Soubor → Uložit jako

Vybrat formát JPEG (*.jpg) a místo, kam se uloží Snímky jako jednotlivé obrázky do složky → Uložit → Všechny snímky ( v dialogu)

Drag and Drop z Průzkumníka

Stiskněte ve složce CRTL + A přetáhněte obrázky z okna Průzkumníka do okna webového prohlížeče s OrgPadem
Můžete všechny najednou, nebo po částech - dle počtu doporučujeme po cca 10, aby jste měli snadné řazení.





digitální interkativní sešit, nástěnka, tabule

Přístupnost
K prezentaci se dostanete odkudkoli, kde máte internet, a za jakéhokoli zařízení - notebooky, tablety, telefony, Windows, Apple, Android, Linux,..
Doporučujeme prohlížeč Safari a Google Chrome!
Místa bez internetu ještě existují? 🤨 Ne, vážně - připravujeme samozřejmě offline verzi OrgPadu, ale ještě nám to chvíli zabere.
Pokud ovšem i tak chcete prezentovat offline, kontaktujte Víta Kalisze a on Vám poradí.
1. Slidy jako obrázky
- méně pracné, velmi rychlé
- nelze vykopírovávat text a ani vyhledávat text v obrázcích
Jak vypadá výsledek vložení pouze obrázků?
Podívejte se na výsledek rovnou v prezentačním režimu. Vpravo nahoře v panelu vyberte Prezentovat a klikněte na Slidy jako obrázky


Možnost komentářů od ostatních
Není to jen prezentace
Prezentační mód je jen jednou z funcionalit OrgPadu.
Primární funkcí je práce s informacemi, myšlenkami a celkově obsahem v souvislostech, v jednom jednoduchém nerušivém plátně. Práce v OrgPadu podporuje kreativitu a dává uživatelům svobodu a pomáhá v dekompozici témat, hledání řešení, analýze a celkově myšlení, kdy máte vše před sebou v kontextu.
Může sloužit jako podklad na rozšíření
V OrgPadu existuje funkce šablony - když ostatním nasdílíte odkaz nebo QR kód na šabonu, otevře se jim Váš materiál v jejich účtu a můžou si do něj psát apod. aniž by měnili Vaši OrgStránku.
Podobně když zveřejníte OrgStránku veřejně nebo i jen pro čtení, si uživatelé, kteří mají přístup, mohou udělat kopii OrgStránky do svého účtu a pracovat s ní.
Proč vůbec mít prezentace v OrgPadu?
Obecně jsou dva způsoby, jak prezentace přenést do OrgPadu
pro ukázku jak oba přístupy vypadají
Máme výchozí soubor
Powerpointová prezentace: přednáška, 2h
Soubor prezentace:
04 - Biologické čištění.pptx
Dopručuji se na něj podívat, aby jste si udělali představu
práce v souvislostech
Agilita - můžu si dělat co chci, kdy a kde chci
V průběhu prezentace se v plátně můžete pohybovat stejně jako mimo prezentační mód. Stejně můžete také otevírat a zavírat viditelné buňky! Stačí pak akorát přejí na další krok prezentace (šipkou na klávesnici, mezerníkem nebo šipkou na panelu ve sdponí části okna na monitoru).
Není lineární, svobodně strukturované

2. Překopírování do buněk OrgPadu
- pracnější řešení, zabere více času
- lze vyhledávat, kopírovat
- dovoluje problematiku více dekomponovat, změnit strukturu a více se přiblížit původní myšlence a síle OrgPadu
Jak vypadá výsledek kopírování do buněk OrgPadu?
Podívejte se na výsledek rovnou v prezentačním režimu. Vpravo nahoře v panelu vyberte Prezentovat a klikněte na Prezentace s buňkami v OrgPadu

Optimální proces kopírování
Otevřít si vedle sebe nebo na dvou monitorech okno Powerpointu a webového prohlížeče s OrgPadem a začít kopírovat. Nebo na jednom monitoru využívat klávesové zkratky ALT + TAB a přeskakovat mezi dvěma okny.
Proces může být různě dlouhý - záleží na způsobu připravení Powerpointové prezentace a její složitosti, na zdatnosti uživatele využívat klávesové zkratky. → Pro potřeby této ukázky kopírování do nového formátu trvalo i s doplněním jiných informací a materiálů pod 30 minut.
Aerobní procesy
- za přítomnosti kyslíku
- aerobní bakterie
Stabilizace
- organická hmota obsažená v kalech
- je stabilizována, zpravidla konverzí na plyny a buněčný materiál.
- Stabilizace může být aerobní nebo anaerobní.

Anaerobní procesy
- za absence kyslíku
- anaerobní bakterie
Selektory
- vynalezeny v bývalém Československu (dnes již existují anoxické a anaerobní modifikace → viz. biologické odstraňování N a P)
- přítokové části aeračního systému
- vyšší koncentrace substrátu
- podpora růstu rychle rostoucích mikroorganismů (nevláknitých)
- potlačení pomalu rostoucích (vláknitých)
- aerační systém s postupným tokem a nízkým zatížením kalu

Odbourání BSK5
- odstranění uhlíkatých org. látek (vznik buněčné hmoty, plynů ...)
Anoxická denitrifikace
- NO3- → N2 , O2
- při nepřítomnosti kyslíku
Chlorování
- využití zvýšené toxicity vůči vláknitým mikroorganizmům s velkým specifickým povrchem (plocha na hmotnostní jednotku)
- plynný chlor nebo chlornan → selektivní potlačení růstu vláknitých mikroorganizmů
- chlor → obvykle do vratného aktiv. kalu
- Účinek se projeví po několikadenním dávkování chloru, po přerušeném dávkování se však kalový index pozvolna opět zvyšuje, a proto je třeba chlorování opakovat.
Fakultativní procesy
- organismy nejsou závislé na přítomnosti rozpuštěného kyslíku
- fakultativní mikroorganismy
Nitrifikace

Denitrifikace
